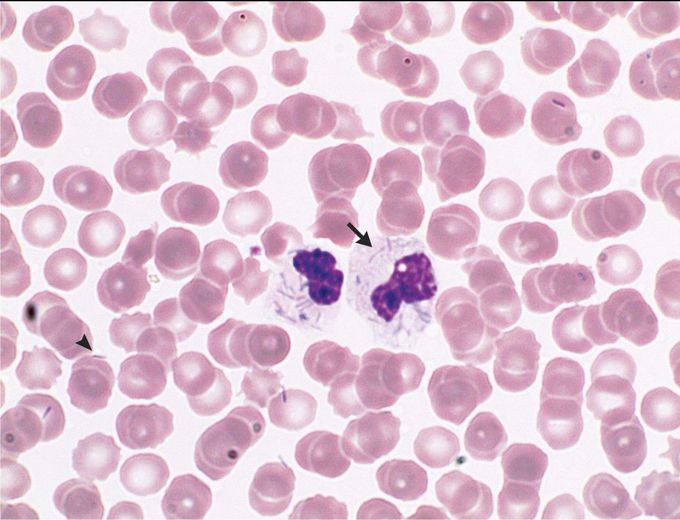
Capnocytophaga canimorsus Infection

Capnocytophaga canimorsus Infection
A 62-year-old man presented to the emergency department with a 1-day history of fever and a 3-day history of chest pain. His medical history was notable for coronary heart disease and for a splenectomy that he had undergone after a car accident. Four days before presentation, he had been bitten on the left hand by his dog and had sustained three bite wounds. Laboratory studies showed a white-cell count of 16,700 per cubic millimeter (reference range, 3900 to 10,200), a platelet count of 31,000 per cubic millimeter (reference range, 150,000 to 370,000), and a procalcitonin level of more than 100 μg per liter (reference value, ≤0.05). Blood cultures were obtained, and treatment with broad-spectrum antibiotic agents, intravenous fluids, and norepinephrine was initiated. Review of a peripheral-blood smear showed the presence of both intracellular (arrow) and extracellular (arrowhead) bacilliform bacteria. Capnocytophaga canimorsus was cultured after 17 hours. C. canimorsus is part of the oral flora of healthy cats and dogs and can be transmitted to humans through animal bites. The bacterium can cause particularly severe infection in patients with a history of splenectomy. Despite treatment, the patient died 2 days after admission.

